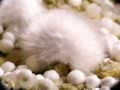
Vignette pour la version du 16 avril 2008 à 17:19

Fichier:Okeinite 1.jpg
Okeinite_1.jpg (600 × 450 pixels, taille du fichier : 106 Kio, type MIME : image/jpeg)
Okeinite et gyrolite, Poonah, Inde
Historique du fichier
Cliquer sur une date et heure pour voir le fichier tel qu'il était à ce moment-là.
| Date et heure | Vignette | Dimensions | Utilisateur | Commentaire | |
|---|---|---|---|---|---|
| actuel | 16 avril 2008 à 17:19 | | 600 × 450 (106 Kio) | Shattukite (discussion | contributions) | Okeinite et gyrolite, Poonah, Inde |
- Vous ne pouvez pas remplacer ce fichier.
Utilisation du fichier
La page suivante utilise ce fichier :
